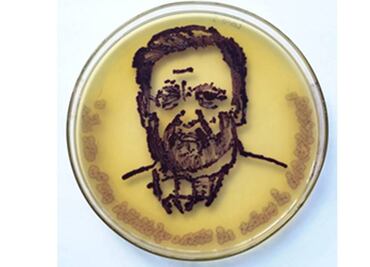
Crean obras de arte con microbios

Francisco Javier Tejeda ha vendido sus obras en EU y Nueva Zelanda. Espera salir de la cárcel el próximo año como beneficio por impartir clases a otros reclusos

Francisco Javier Tejeda ha vendido sus obras en EU y Nueva Zelanda. Espera salir de la cárcel el próximo año como beneficio por impartir clases a otros reclusos
Científicos resaltaron la belleza oculta en las bacterias

A la cabeza de la lista se encuentra “Les Femmes d’Alger” de Pablo Picasso, que costó en subasta 179 millones de dólares

Son pinturas y litografías de artistas españoles y europeos

Se trata de un comprador chino que también adquirió otras siete piezas atribuidas al dictador alemán

14 acuarelas y dibujos de Hitler fueron vendidos en Alemania

La casa Weidler indicó que los precios de salida por varias obras del dictador nazi oscilan entre los mil y los 45 mil euros

Algunos compuestos químicos usados por el impresionista holandés están generando la pérdida de pigmento por la formación de cristales blancos